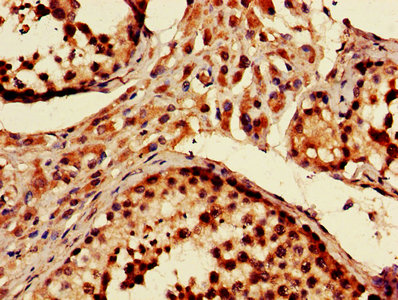
CSB-PA017451LA01HU

PRKN
PRKN,全名為parkin RBR E3泛素蛋白連接酶,也被稱為帕金蛋白。該蛋白是細(xì)胞內(nèi)重要的“質(zhì)檢員”,通過(guò)識(shí)別并標(biāo)記異常蛋白質(zhì),引導(dǎo)細(xì)胞清理系統(tǒng)清除受損組分,維持細(xì)胞內(nèi)環(huán)境的穩(wěn)定。PRKN蛋白參與多個(gè)生理過(guò)程,包括細(xì)胞對(duì)氨基酸刺激的響應(yīng)、神經(jīng)元死亡的負(fù)調(diào)控以及突觸傳遞的負(fù)調(diào)控。在神經(jīng)元死亡負(fù)調(diào)控的上游或內(nèi)部發(fā)揮作用,位于膜性器官的邊界膜、膜筏以及突觸后密度等細(xì)胞組件中,并與線粒體共定位。PRKN蛋白的研究對(duì)于理解帕金森病、2型糖尿病等疾病具有重要意義,其人類同源物與帕金森病、帕金森病2和卵巢癌有關(guān)。目前,針對(duì)PRKN蛋白的藥物研發(fā)尚處于早期階段,但已有研究表明,PRKN蛋白的異常可能與帕金森病的發(fā)生發(fā)展密切相關(guān)。
熱銷產(chǎn)品
Recombinant Human E3 ubiquitin-protein ligase parkin (PRKN) (CSB-BP017451HU)
驗(yàn)證數(shù)據(jù)

(Tris-Glycine gel) Discontinuous SDS-PAGE (reduced) with 5% enrichment gel and 15% separation gel.
PRKN Recombinant Monoclonal Antibody (CSB-RA199844A0HU)
驗(yàn)證數(shù)據(jù)

Western Blot
Positive WB detected in: SH-SY5Y whole cell lysate(30μg), U-251MG whole cell lysate(30μg), Jurkat whole cell lysate(30μg), K562 whole cell lysate(30μg), HEK293 whole cell lysate(30μg), HEK293T whole cell lysate(30μg), SW620 whole cell lysate(30μg)
All lanes: Parkin antibody at 1:1000
Secondary
Goat polyclonal to rabbit IgG at 1/50000 dilution
Predicted band size: 52 kDa
Observed band size: 30 kDa
Exposure time: 2min

Immunofluorescence staining of A-549 cell with CSB-RA199844A0HU at 1:50, counter-stained with DAPI. The cells were fixed in 4% formaldehyde, permeabilized using 0.2% Triton X-100 and blocked in 10% normal Goat Serum. The cells were then incubated with the antibody overnight at 4°C. The secondary antibody was Alexa Fluor 488-congugated AffiniPure Goat Anti-Rabbit IgG(H+L).

Overlay Peak curve showing 786-O cells stained with CSB-RA199844A0HU (red line) at 1:100. The cells were fixed in 4% formaldehyde and permeated by 0.2% TritonX-100 for 10min. Then 10% normal goat serum to block non-specific protein-protein interactions followed by the antibody (1ug/1*106cells) for 45min at 4℃. The secondary antibody used was FITC-conjugated goat anti-rabbit IgG (H+L) at 1/200 dilution for 35min at 4℃.Control antibody (green line) was Rabbit IgG (1ug/1*106cells) used under the same conditions. Acquisition of >10,000 events was performed.
PRKN Antibody (CSB-PA017451LA01HU)
驗(yàn)證數(shù)據(jù)

Western Blot
Positive WB detected in: HepG2 whole cell lysate, SH-SY5Y whole cell lysate, Jurkat whole cell lysate
All lanes: PRKN antibody at 3µg/ml
Secondary
Goat polyclonal to rabbit IgG at 1/50000 dilution
Predicted band size: 52, 49, 24, 31, 43, 36, 44, 47 kDa
Observed band size: 52 kDa
IHC image of CSB-PA017451LA01HU diluted at 1:600 and staining in paraffin-embedded human testis tissue performed on a Leica BondTM system. After dewaxing and hydration, antigen retrieval was mediated by high pressure in a citrate buffer (pH 6.0). Section was blocked with 10% normal goat serum 30min at RT. Then primary antibody (1% BSA) was incubated at 4°C overnight. The primary is detected by a biotinylated secondary antibody and visualized using an HRP conjugated SP system.

IHC image of CSB-PA017451LA01HU diluted at 1:600 and staining in paraffin-embedded human adrenal gland tissue performed on a Leica BondTM system. After dewaxing and hydration, antigen retrieval was mediated by high pressure in a citrate buffer (pH 6.0). Section was blocked with 10% normal goat serum 30min at RT. Then primary antibody (1% BSA) was incubated at 4°C overnight. The primary is detected by a biotinylated secondary antibody and visualized using an HRP conjugated SP system.

Immunofluorescent analysis of PC-3 cells using CSB-PA017451LA01HU at dilution of 1:100 and Alexa Fluor 488-congugated AffiniPure Goat Anti-Rabbit IgG(H+L)
PRKN Antibodies
PRKN for Homo sapiens (Human)
| 產(chǎn)品貨號(hào) | 產(chǎn)品名稱 | 種屬反應(yīng)性 | 應(yīng)用類型 |
|---|---|---|---|
| CSB-PA017451LA01HU | PRKN Antibody | Human | ELISA, WB, IHC, IF |
| CSB-PA076233 | PARK2 Antibody | Human,Mouse,Rat | ELISA,WB,IHC |
| CSB-PA003708 | PARK2 Antibody | Human | WB, IHC, ELISA |
| CSB-PA020235 | Phospho-PARK2 (S131) Antibody | Human | WB, IHC, ELISA |
| CSB-PA020236 | PARK2 Antibody | Human,Mouse,Rat | WB, IHC, IF, ELISA |
| CSB-RA199844A0HU | PRKN Recombinant Monoclonal Antibody | Human | ELISA, WB, IF, FC |
PRKN Proteins
PRKN Proteins for Homo sapiens (Human)
| 產(chǎn)品貨號(hào) | 產(chǎn)品名稱 | 來(lái)源 |
|---|---|---|
| CSB-YP017451HU CSB-MP017451HU CSB-EP017451HU-B |
Recombinant Human E3 ubiquitin-protein ligase parkin (PRKN) | Yeast Mammalian cell In Vivo Biotinylation in E.coli |
| CSB-EP017451HU | Recombinant Human E3 ubiquitin-protein ligase parkin (PRKN) | E.coli |
| CSB-BP017451HU | Recombinant Human E3 ubiquitin-protein ligase parkin (PRKN) | Baculovirus |
| CSB-BP017451HUb1 | Recombinant Human E3 ubiquitin-protein ligase parkin (PRKN) | Baculovirus |
PRKN Proteins for Rattus norvegicus (Rat)
| 產(chǎn)品貨號(hào) | 產(chǎn)品名稱 | 來(lái)源 |
|---|---|---|
| CSB-YP864348RA CSB-EP864348RA CSB-MP864348RA CSB-EP864348RA-B |
Recombinant Rat E3 ubiquitin-protein ligase parkin (Park2) | Yeast E.coli Mammalian cell In Vivo Biotinylation in E.coli |
| CSB-EP864348RAb1 | Recombinant Rat E3 ubiquitin-protein ligase parkin (Park2) | E.coli |
| CSB-BP864348RA | Recombinant Rat E3 ubiquitin-protein ligase parkin (Prkn) | Baculovirus |
PRKN Proteins for Mus musculus (Mouse)
| 產(chǎn)品貨號(hào) | 產(chǎn)品名稱 | 來(lái)源 |
|---|---|---|
| CSB-YP893911MO CSB-BP893911MO CSB-MP893911MO CSB-EP893911MO-B |
Recombinant Mouse E3 ubiquitin-protein ligase parkin (Prkn) | Yeast Baculovirus Mammalian cell In Vivo Biotinylation in E.coli |
PRKN Proteins for Mus musculus(Mouse)
| 產(chǎn)品貨號(hào) | 產(chǎn)品名稱 | 來(lái)源 |
|---|---|---|
| CSB-EP893911MO | Recombinant Mouse E3 ubiquitin-protein ligase parkin (Prkn) | E.coli |
















